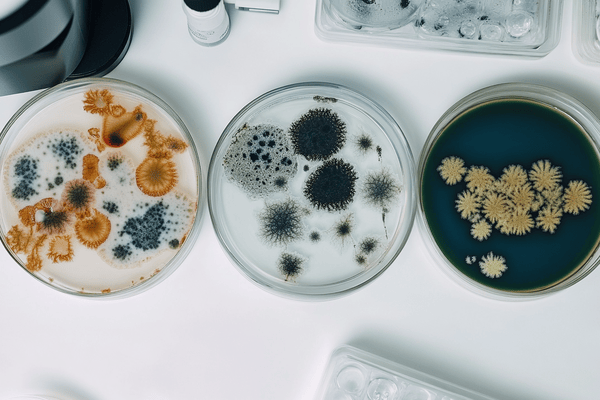
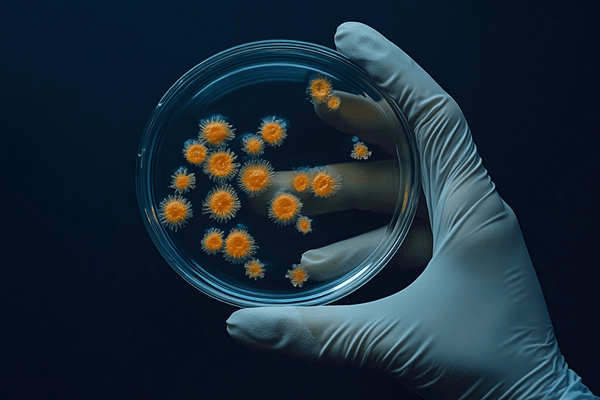

(703) 992–9480
ConstructionRisk, LLC
1950 Old Gallows Rd.
Ste. 750
Tysons Corner, VA 22182
Kent Holland
Principal
Mr. Holland wrote on design liability legal trends and now writes on environmental issues for IRMI.com.
As Managing Principal of ConstructionRisk.com LLC, Mr. Holland provides construction and environmental risk management services. His consulting services include assisting clients in risk management and legal issues in all phases of construction projects, including drafting and negotiating contracts, preparing change order and claim documentation, analyzing changes and claims, insurance risk management, and environmental risk management. His risk management clients have included several insurers, as well as design professionals, environmental consultants, design-builders, contractors, project owners, and developers.
He is also a construction lawyer with the firm of ConstructionRisk Counsel, PLLC, with a national practice emphasizing construction and environmental law—representing project owners, design professionals, and construction contractors in contract negotiations, claim resolution, disputes, and litigation.
From 1982 through 1986, he was an attorney in the Office of General Counsel of the US Environmental Protection Agency, with responsibility for assisting the agency in deciding wastewater treatment construction grants disputes, contractor claims, bid protests, suspension and debarment matters, and minority business enterprise matters.
Mr. Holland is a frequent speaker for groups such as the American Bar Association and IRMI on the subjects of environmental law, insurance law, and construction law, with a special emphasis on risk management for design professionals and contractors. He has written several books, including Contract Guide for Design Professionals (2012); Working of Purpose (2011); Risk Management for Design Professionals in a World of Change (2010); Construction Law & Risk Management—Case Notes and Articles, Vol. II (2006); Risk Management & Contract Guide for Design Professionals (2006); Construction Law & Risk Management—Case Notes and Articles (2003); Architectural/Engineering Contracts Risk Management Guide (1997); and EPA Construction Grants Disputes: Surviving the Audit (1990). He has also written chapters in several manuals and books for publishers including Wiley Law, Aspen Law, and IRMI. He coauthored and edited Construction Contractor's Environmental Risk Management Procedures Manual for the Associated General Contractors Association of America (AGC). He has taught a Federal Publications course titled "The Environmental Liabilities of Government Contractors and Agencies."
Mr. Holland publishes a Web-based construction risk management library and legal newsletter at www.ConstructionRisk.com. He is a 1979 graduate of the Villanova University School of Law. When not working, you will find Kent on his motorcycle, bicycle, or snowboard or playing tennis.
Articles

Design and Professional Liability